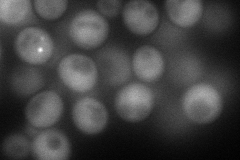
YFR025C
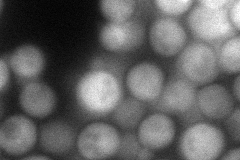
YFR025C
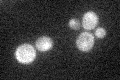
YFR025C

View description
Histidinolphosphatase, catalyzes the eighth step in histidine biosynthesis; mutations cause histidine auxotrophy and sensitivity to Cu, Co, and Ni salts; transcription is regulated by general amino acid control
Localization:
Intensity:
Fold change:
Significance:
-
C’ GFP library in SD

cytosol30.71 -
N' NOP1pr-GFP in SD
cytosol,punctate96.9694 -
N' TEF2pr-mCherry in SD
cytosol60.3335 -
N' NATIVEpr-GFP in SD

below threshold23.1652 -
N' TEF2pr-VC and Cyto-VN in SD

below threshold28.9897 -
C’ GFP library in SD+DTT

cytosol26.160.85No -
C’ GFP library in SD+H2O2

cytosol27.770.9No -
C’ GFP library in Starvation Media
cytosol40.091.3No -
C’ GFP library on the background of Pup2-DaMP

cytosol -
C’ GFP library on the background of CCT mutant

cytosol36.04191.17349No
